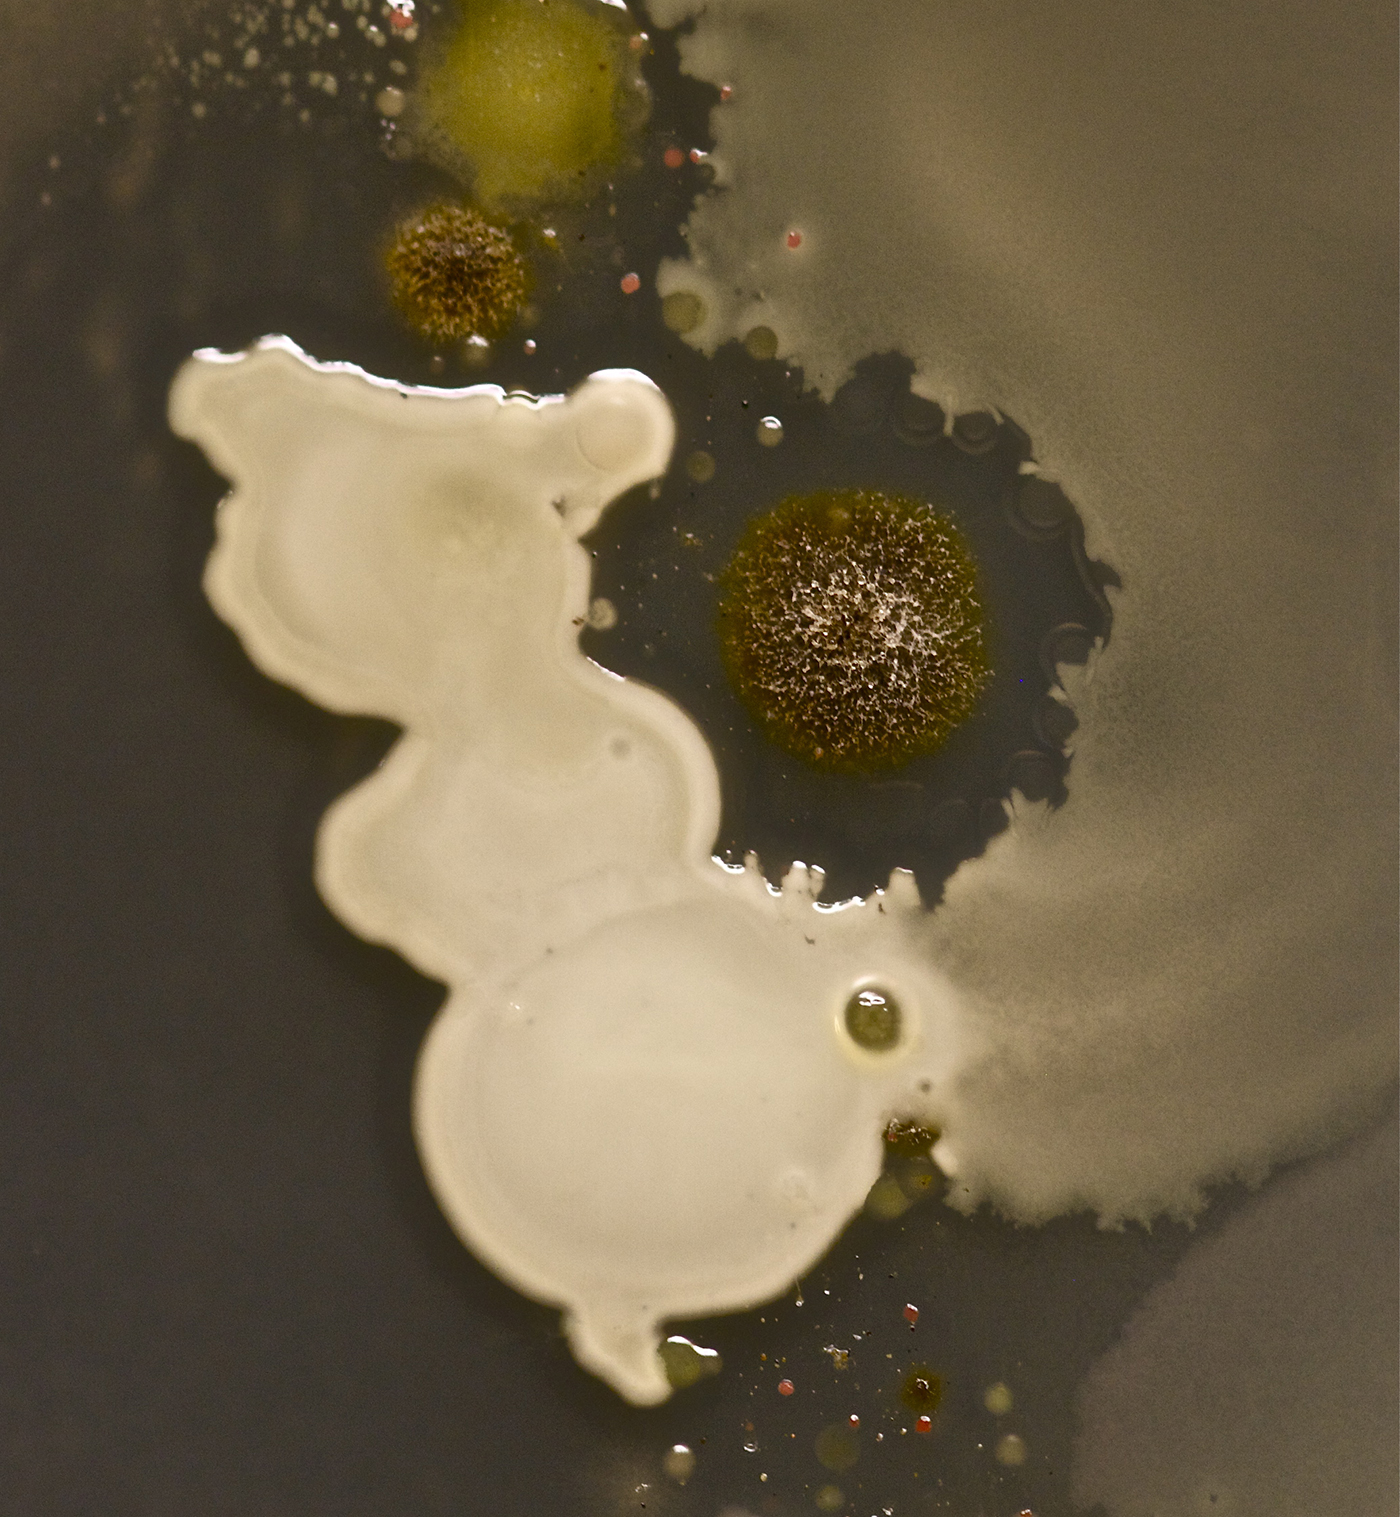
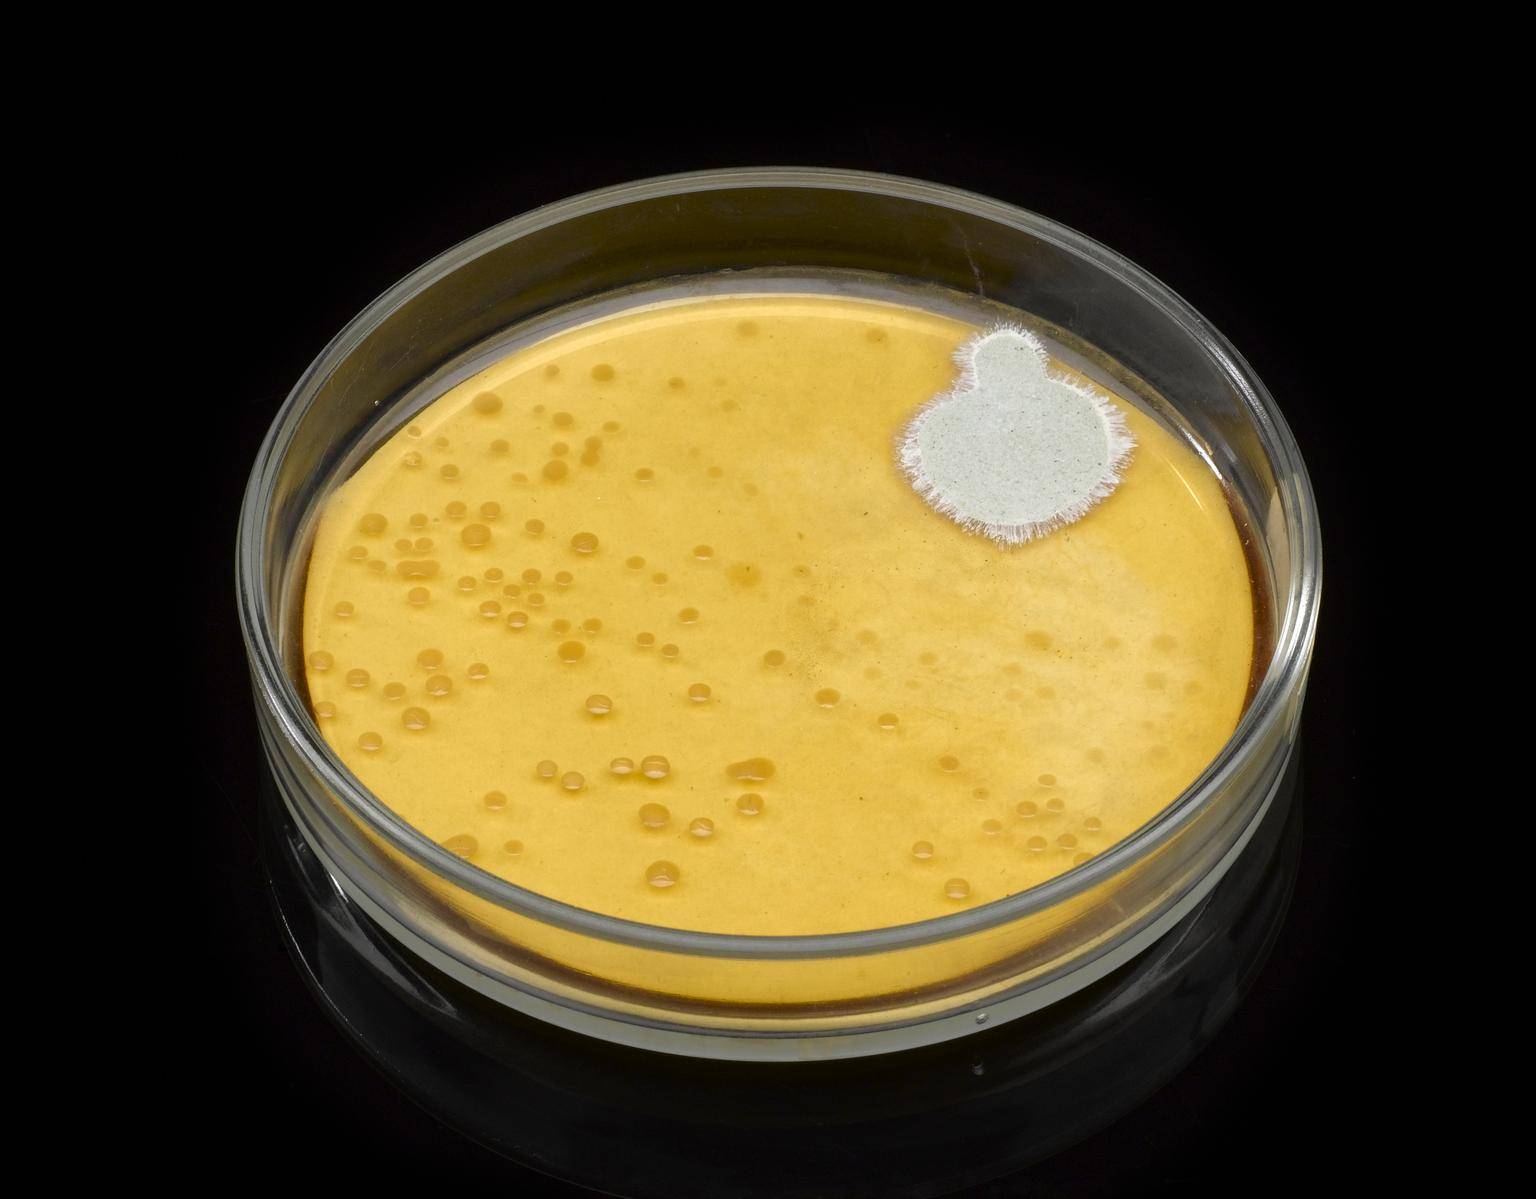

Ons lichaam kan om verschillende redenen ziek worden, bijvoorbeeld door erfelijke aanleg of door een ongezonde levensstijl. We kunnen ook ziek worden doordat er lichaamsvreemde organismen ons lichaam binnendringen, zoals bacteriën, virussen en andere parasieten. Als ons afweersysteem onvoldoende in staat is deze indringers onschadelijk te maken, worden we ziek. Een arts kan in dat geval besluiten om antibiotica voor te schrijven. Tenminste: als de infectie wordt veroorzaakt door bacteriën. De werking van antibiotica is namelijk gebaseerd op het effect van bepaalde stoffen uit schimmels op bepaalde bacteriën. Hoe werkt de interactie tussen deze twee micro-organismen?
Schimmels
Schimmels zijn micro-organismen, levende wezentjes zonder weefsels of organen die alleen onder een microscoop zichtbaar zijn. Schimmels kunnen eencellig zijn, zoals gisten, maar ook uit meerdere cellen bestaan. In dat geval vormen de cellen lange draden, die hyfen worden genoemd. De draden vertakken zich en groeien uit over of in een voedingsbodem. Op dat moment wordt de schimmel zichtbaar voor het blote oog, zoals op beschimmeld brood. Door de draden zien schimmels er vaak stoffig, wollig of harig uit, wat de schimmel zijn typische uiterlijk geeft.
Schimmels zijn micro-organismen die zich door middel van sporen via de lucht vermeerderen
Alle hyfen samen wordt het mycelium genoemd. In de draden, of aan de uiteinden ervan, worden sporen gevormd. Vaak zijn deze sporen gekleurd, terwijl het mycelium wit is. Wanneer de sporen rijp zijn, laten ze los. Daardoor komen ze in de lucht terecht, waar ze door luchtstromen worden meegevoerd, op zoek naar gunstige omstandigheden om een nieuwe schimmelkolonie te vormen. Zo vermeerdert de schimmel zich.

Kweekschaaltje met verschillende soorten schimmel. Foto: Shutterstock.
Net als ieder ander organisme heeft een schimmel voedsel nodig om in leven te blijven. Sommige schimmelsoorten voeden zich met andere levende organismen, andere juist met dode organismen. De eerste soort worden parasieten genoemd. Een parasitaire schimmel leeft bijvoorbeeld in een boom, die daardoor langzaam wegrot. De tweede groep schimmels, die zich met dode organismen voedt, worden de saprofyten genoemd. Zonder deze schimmels zouden plantresten en dode dieren niet worden afgebroken en ‘opgeruimd’, maar voor eeuwig blijven liggen.
Schimmels voeden zich met levende of met dode organismen en kunnen schadelijk of nuttig zijn
Sommige schimmels maken bij de juiste luchtvochtigheid en temperatuur gifstoffen aan, die mycotoxines worden genoemd. Sommige van deze mycotoxines zijn schadelijk voor zowel de mens als voor andere organismen. Moederkoorn is bijvoorbeeld een schimmel die rogge en tarwe aantast. Als iemand meel eet dat gemaakt is van besmette aren van deze granen, loopt diegene kans de kriebelziekte (ofwel ergotisme) te krijgen. Andere mycotoxines zijn juist niet schadelijk voor de mens, maar wel voor andere organismen. Penicilline is hier een goed voorbeeld van: deze mycotoxine doodt bacteriën, maar een mensenleven kan er juist door gered worden.
Time-lapsevideo van de groei van de hyfen en sporen van een kolonie Penicillium chrysogenum Thom. Na verloop van tijd scheidt de schimmel de mycotoxine penicilline af, die in druppels bovenop het schimmeldek ligt. Voor deze clip werd gedurende veertien dagen elke vijftien minuten één frame gefilmd. De totale beeldenserie wordt hier 22.500 keer versneld afgespeeld. Video: Science Photo Library. Videograaf: Wim van Egmond. © Science Photo Library.
Schimmels kunnen dus schadelijk, maar ook heel nuttig zijn. Sommige schimmels zijn zelfs eetbaar, zoals gist. Deze schimmel wordt gebruikt om brood te laten rijzen en om de suikers in bier en wijn om te zetten in alcohol en koolzuurgas. Ook het van oorsprong Engelse broodbeleg Marmite bevat gist, terwijl sojasaus, sake en salami weer andere schimmels bevatten. En tot slot zijn er natuurlijk nog paddenstoelen als champignons, eekhoorntjesbrood en truffels, de eetbare vruchtlichamen van bepaalde schimmels.
Bacteriën
Net als schimmels zijn bacteriën micro-organismen. Je kunt ze dus alleen zien onder een microscoop die minstens duizend keer vergroot. Net als schimmels zijn bacteriën overal aanwezig: op de toiletbril, de afstandsbediening, je toetsenbord, je telefoon en je schoenen, maar ook op je huid en in je darmen. Sommige bacteriën kunnen zelfs onder extreme omstandigheden overleven zoals in vulkanen of in de diepzee!

In 2015 maakte Tasha Sturm, een Amerikaanse microbiologe, deze handafdruk van haar toen achtjarige zoontje nadat hij buiten had gespeeld. Na een aantal dagen waren er in het kweekschaaltje allerlei verschillende bacteriën, schimmels en gisten te zien. Foto: Tasha Sturm, Cabrillo College. Fotograaf: Tasha Sturm. © Tasha Sturm, Cabrillo College.
Een bacterie bestaat uit één cel, die eruit ziet als een bolletje, staafje, kommatje of spiraaltje. Een bacterie vermeerdert zich door middel van celdeling. Dat wil zeggen dat uit één bacterie na verloop van tijd twee bacteriën onstaan, die zich vervolgens ook delen, waarna er vier bacterien zijn. Dit gebeurt meestal elke twintig minuten. Wat begint met één bacterie, kan door deze exponentiële groei dus binnen een halve dag vermeerderen tot miljarden bacteriën. Op dat moment zijn de bacterïen met het blote oog te zien.
Bacteriën zijn micro-organismen die zich door middel van celdeling razendsnel kunnen vermenigvuldigen
Bacteriën verschillen niet alleen in vorm maar ook in celwand: sommige bacteriesoorten hebben een dikke celwand, andere een dunne. Om de dikte van de celwand te bepalen wordt een methode gebruikt die gramkleuring wordt genoemd. De methode werd in 1884 ontwikkeld door de Deense microbioloog Hans Christian Gram (1853-1938) en kleurt bacteriën met behulp van verschillende vloeistoffen. Bacteriën met een dunne celwand kleuren lichtrood, terwijl bacteriën met een dikke celwand blauwpaars kleuren. De lichtrode bacteriën worden gramnegatief genoemd, de blauwpaarse grampositief.

Gramkleuring toegepast op de grampositieve bacterie Staphylococcus aureus (blauwpaars) en de gramnegatieve bacterie Escherichia coli (lichtrood), gezien door een microscoop die duizend keer vergroot. Foto: Flickr. Fotograaf: Marc Perkins. CC BY-NC 2.0. Bewerkt.
Het overgrote deel van de bacteriën is niet schadelijk voor de mens. Integendeel: ze vormen een essentieel onderdeel van onze afweer en spelen een belangrijke rol in onze spijsvertering. Andere bacteriesoorten maken zich nuttig door bijvoorbeeld net als schimmels voor de afbraak van dode planten en dieren te zorgen. Bij de bereiding van voedingsmiddelen als yoghurt, kaas, azijn, zuurkool en kimchi worden ook bacteriën gebruikt, terwijl aan producten als Actimel®, Activia® en Yakult® zelfs bepaalde bacteriesoorten worden toegevoegd omdat deze de gezondheid zouden bevorderen.
Een groot deel van de bacteriën is niet schadelijk voor de mens, maar sommige veroorzaken ziekten
Er zijn echter ook bacteriën die ziekten kunnen veroorzaken als kinkhoest, tuberculose en gonorroe. Als zo’n schadelijke bacterie het lichaam binnendringt en door het lichaam als een lichaamsvreemde stof wordt herkend, wordt het afweersysteem van de mens geactiveerd. Er worden antistoffen aangemaakt om de bacterie te bestrijden. Als het immuunsysteem de bacterie tijdig uitschakelt, is de persoon alleen besmet en heeft hij of zij geen klachten. Als het immuunsysteem onvoldoende in staat is om de bacterie uit te schakelen is er sprake van een bacteriële infectie. In het ergste geval heeft zo’n infectie voor het slachtoffer een dodelijke afloop.
Een niet-geïdentificeerde schimmel, omgeven door twee verschillende bacteriën. Rondom de schimmel is de zogenaamde remmingszone duidelijk zichtbaar. In deze halo wordt de groei van de bacteriën geremd door de aanwezigheid van de schimmel. Foto: Tasha Sturm, Cabrillo College. Fotograaf: Tasha Sturm. © Tasha Sturm, Cabrillo College.
Antibiotica
Eeuwenlang was er vrijwel geen remedie tegen bacteriële infecties. Een geïnfecteerd wondje kon al fataal zijn. Pas in de twintigste eeuw kwamen er voor het eerst op grotere schaal geneesmiddelen beschikbaar waarmee de mens snel en effectief dodelijke bacteriële infecties kon voorkomen en behandelen. Deze medicijnen werden later ‘antibiotica’ genoemd. De werkzame stoffen in deze middelen zijn ook nu nog afgeleid van natuurlijke grondstoffen: de mycotoxines die door verschillende schimmels worden geproduceerd worden verzameld, in de meeste gevallen chemisch gemodificeerd en samen met een aantal hulpstoffen tot geneesmiddel gemaakt.
Sommige antibiotica worden van oorsprong geproduceerd door een schimmel en werken tegen een of meerdere bacteriën
Elk antibioticum werkt tegen een of meerdere bacteriën of bacteriegroepen. De keuze voor een antibioticum hangt af van de bacterie of bacteriegroep die bestreden moet worden. Zogenaamde smalspectrum antibiotica werken tegen infecties die worden veroorzaakt door óf grampositieve óf gramnegatieve bacteriën. Breedspectrum antibiotica werken juist tegen beide groepen bacteriën. Alle antibiotica hebben echter hetzelfde doel: het doden van bacteriën of het remmen van bacteriën in hun groei. In combinatie met het immuunsysteem van de patiënt gaat de infectie dan over.

Moderne antibiotica in verschillende toedieningsvormen. Achter, v.l.n.r.:
Granulaat (korreltjes) met claritromycine, geproduceerd door Sandoz, 2018. Bedoeld om met water te mengen tot een drankje voor orale toediening.
Capsules met amoxicilline, geproduceerd door Mylan, 2018. Bedoeld voor orale toediening.
Poeder met amoxicilline en clavulaanzuur, geproduceerd door Sandoz, 2018. Bedoeld om met water te mengen tot een drankje voor orale toediening.
Voor, v.l.n.r.:
Filmomhulde tabletten met ciprofloxacine, geproduceerd door Accord, 2018. Bedoeld voor orale toediening.
Poeder met amoxicilline, geproduceerd door Centrafarm, 2018. Bedoeld om met gedestilleerd water te mengen tot een oplossing voor toediening via injectie of infuus.
Capsules met nitrofurantoïne, geproduceerd door Apotex, 2018. Bedoeld voor orale toediening.
Foto: Stichting Farmaceutisch Erfgoed. Fotograaf: Studio-Oost. CC BY-NC-SA 3.0.
Een gezond lichaam is in staat zelfstandig te herstellen van de meeste bacteriële infecties. Medicatie is dan niet nodig. Maar als de patiënt bijvoorbeeld niet genoeg weerstand heeft, kan de arts besluiten om een antibioticum voor te schrijven. Het antibioticum doodt een groot deel van de bacteriën of remt ze in hun groei, tot het lichaam weer voldoende weerstand heeft om zelf de resterende bacteriën uit te schakelen. Bij de behandeling van ernstige bacteriële infecties, zoals longontsteking, hersenvliesontsteking en bloedvergiftiging, zijn antibiotica echter noodzakelijk. Het lichaam is namelijk zelden in staat om daarvan op eigen kracht te herstellen.
Als een patiënt een bacteriële infectie heeft, kan de arts een antibioticum voorschrijven om het afweersysteem te helpen
Wanneer een arts een antibioticum voorschrijft voor een bacteriële infectie, wordt niet alleen de bacterie die de infectie veroorzaakt aangepakt, maar ook de nuttige bacteriën die de mens bij zich draagt, bijvoorbeeld in de darmen. Diarree is dan ook een vaak voorkomende bijwerking van antibioticagebruik, vooral wanneer er een breedspectrum middel is voorgeschreven. Om dit soort bijwerkingen zoveel mogelijk te beperken geeft de arts indien mogelijk altijd de voorkeur aan een behandeling met smalspectrum antibiotica.